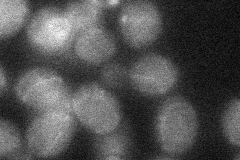
YOL110W
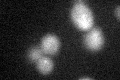
YOL110W

View description
Subunit of a palmitoyltransferase, composed of Shr5p and Erf2p, that adds a palmitoyl lipid moiety to heterolipidated substrates such as Ras1p and Ras2p through a thioester linkage; palmitoylation is required for Ras2p membrane localization
Localization:
Intensity:
Fold change:
Significance:
-
C’ GFP library in SD

below threshold17.34 -
N' NOP1pr-GFP in SD

ER49.8979 -
N' TEF2pr-mCherry in SD

ER,vacuole37.1001 -
N' NATIVEpr-GFP in SD

below threshold19.4932 -
N' TEF2pr-VC and Cyto-VN in SD
below threshold25.9632 -
C’ GFP library in SD+DTT
cytosol19.931.14No -
C’ GFP library in SD+H2O2

cytosol17.381No -
C’ GFP library in Starvation Media

cytosol19.241.1No -
C’ GFP library on the background of Pup2-DaMP

below threshold -
C’ GFP library on the background of CCT mutant

below threshold17.57621.01326No
